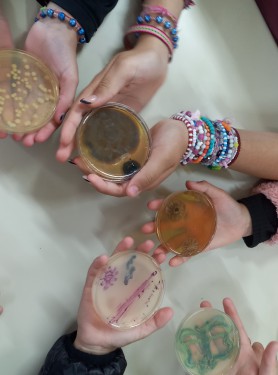

Curitiba, 05 de junho de 2026
Ciêntistas na escola
No dia 30 de outubro, quinta-feira de manhã, os estudantes dos 5° anos A/B e C juntamente com a professora Denise na prática de ciências e tecnologia, participaram do projeto, cientista na escola, os cientistas apresentaram vários tipos de fungos, bactérias e alimentação saudável.
Estiveram presentes quatro cientistas da UFPR, eles aplicaram um desafio de sorte ou azar, sobre alimentação saudável. E realizaram uma apresentação sobre caries com fantoches, onde eles representavam: uma fada do dente, uma menina, um dente e a carie, e o objetivo dessa apresentação era ensinar que todos os dias devemos escovar os dentes.
E no fim da apresentação todos os alunos ganharam um broche. Todos nós dos quintos anos gostamos bastante, e aprendemos muito com cada experimento e explicação.
Autor: A. B. T.
Idade: 12 anos
Postado em: 18/11/2025
Fonte: E.M. CEI Ulysses S. Guimarães - EF
noticias
5 comentário(s)